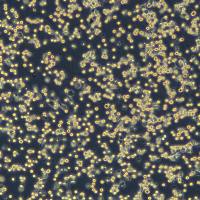
浙江美森-人红白细胞白血病细胞 HEL

相关产品推荐更多 >
万千商家帮你免费找货
0 人在求购买到急需产品
- 详细信息
- 技术资料
- 英文名:
PC-9(Luc1)
- 库存:
99
- 细胞类型:
详询
- 品系:
详询
- 组织来源:
详询
- 相关疾病:
详询
- 物种来源:
详询
- 免疫类型:
详询
- 细胞形态:
详询
- 器官来源:
详询
- 运输方式:
顺丰包邮
- 年限:
详询
- 生长状态:
详询
- 规格:
T25
产品描述
种属: 人源(Homo sapiens)
组织来源: 肺(Lung)
疾病: 癌症(Carcinoma)
年龄: 45岁(45years)
性别: 男(Male)
细胞类型: 表皮细胞(Epithelial)
生长特性: 贴壁生长(Adherent)
完全培养基配制
该细胞系培养所用基本培养基为RPMI1640 Medium,配置完全培养基时需加入10%FBS,1% Anti-Anti。该细胞系为puro 抗性,可根据需要加入1ug/mL puromycin。
细胞介绍
PC-9 (Luc) 是一种经过基因工程改造、稳定表达荧光素酶(Luciferase)的人肺腺癌细胞系。其亲本PC-9细胞源自一位日本肺腺癌患者的原发肿瘤组织,是研究表皮生长因子受体(EGFR)靶向治疗的“金标准”模型。该细胞最显著的特征是携带EGFR基因第19号外显子缺失突变(Exon 19 E746-A750del),这一突变导致其对第一代EGFR酪氨酸激酶抑制剂(如吉非替尼、厄洛替尼)高度敏感,但也会在药物压力下最终产生获得性耐药(如T790M突变)。
通过引入Luc报告基因,该细胞在注入底物荧光素后能够产生强烈的生物发光信号。这一特性使其成为在活体内实时、定量追踪肿瘤动态的完美工具。在移植到免疫缺陷小鼠体内后,研究人员可利用活体成像系统(IVIS)非侵入性地精准监测肿瘤的生长、对EGFR-TKI药物的快速治疗反应、微小残留病灶的持续存在以及耐药性复发的过程。
因此,PC-9 (Luc) 被广泛应用于高通量筛选EGFR靶向药物、深入研究TKI耐药机制、评估克服耐药的联合治疗策略(如联合化疗或其他靶向药),并为开发新一代EGFR抑制剂提供了至关重要的临床前研究平台,极大地推动了肺癌精准医疗的发展。
风险提示:丁香通仅作为第三方平台,为商家信息发布提供平台空间。用户咨询产品时请注意保护个人信息及财产安全,合理判断,谨慎选购商品,商家和用户对交易行为负责。对于医疗器械类产品,请先查证核实企业经营资质和医疗器械产品注册证情况。
技术资料暂无技术资料 索取技术资料
浙江(杭州)美森 人肺腺癌细胞PC-9(Luc1)现货
¥4600